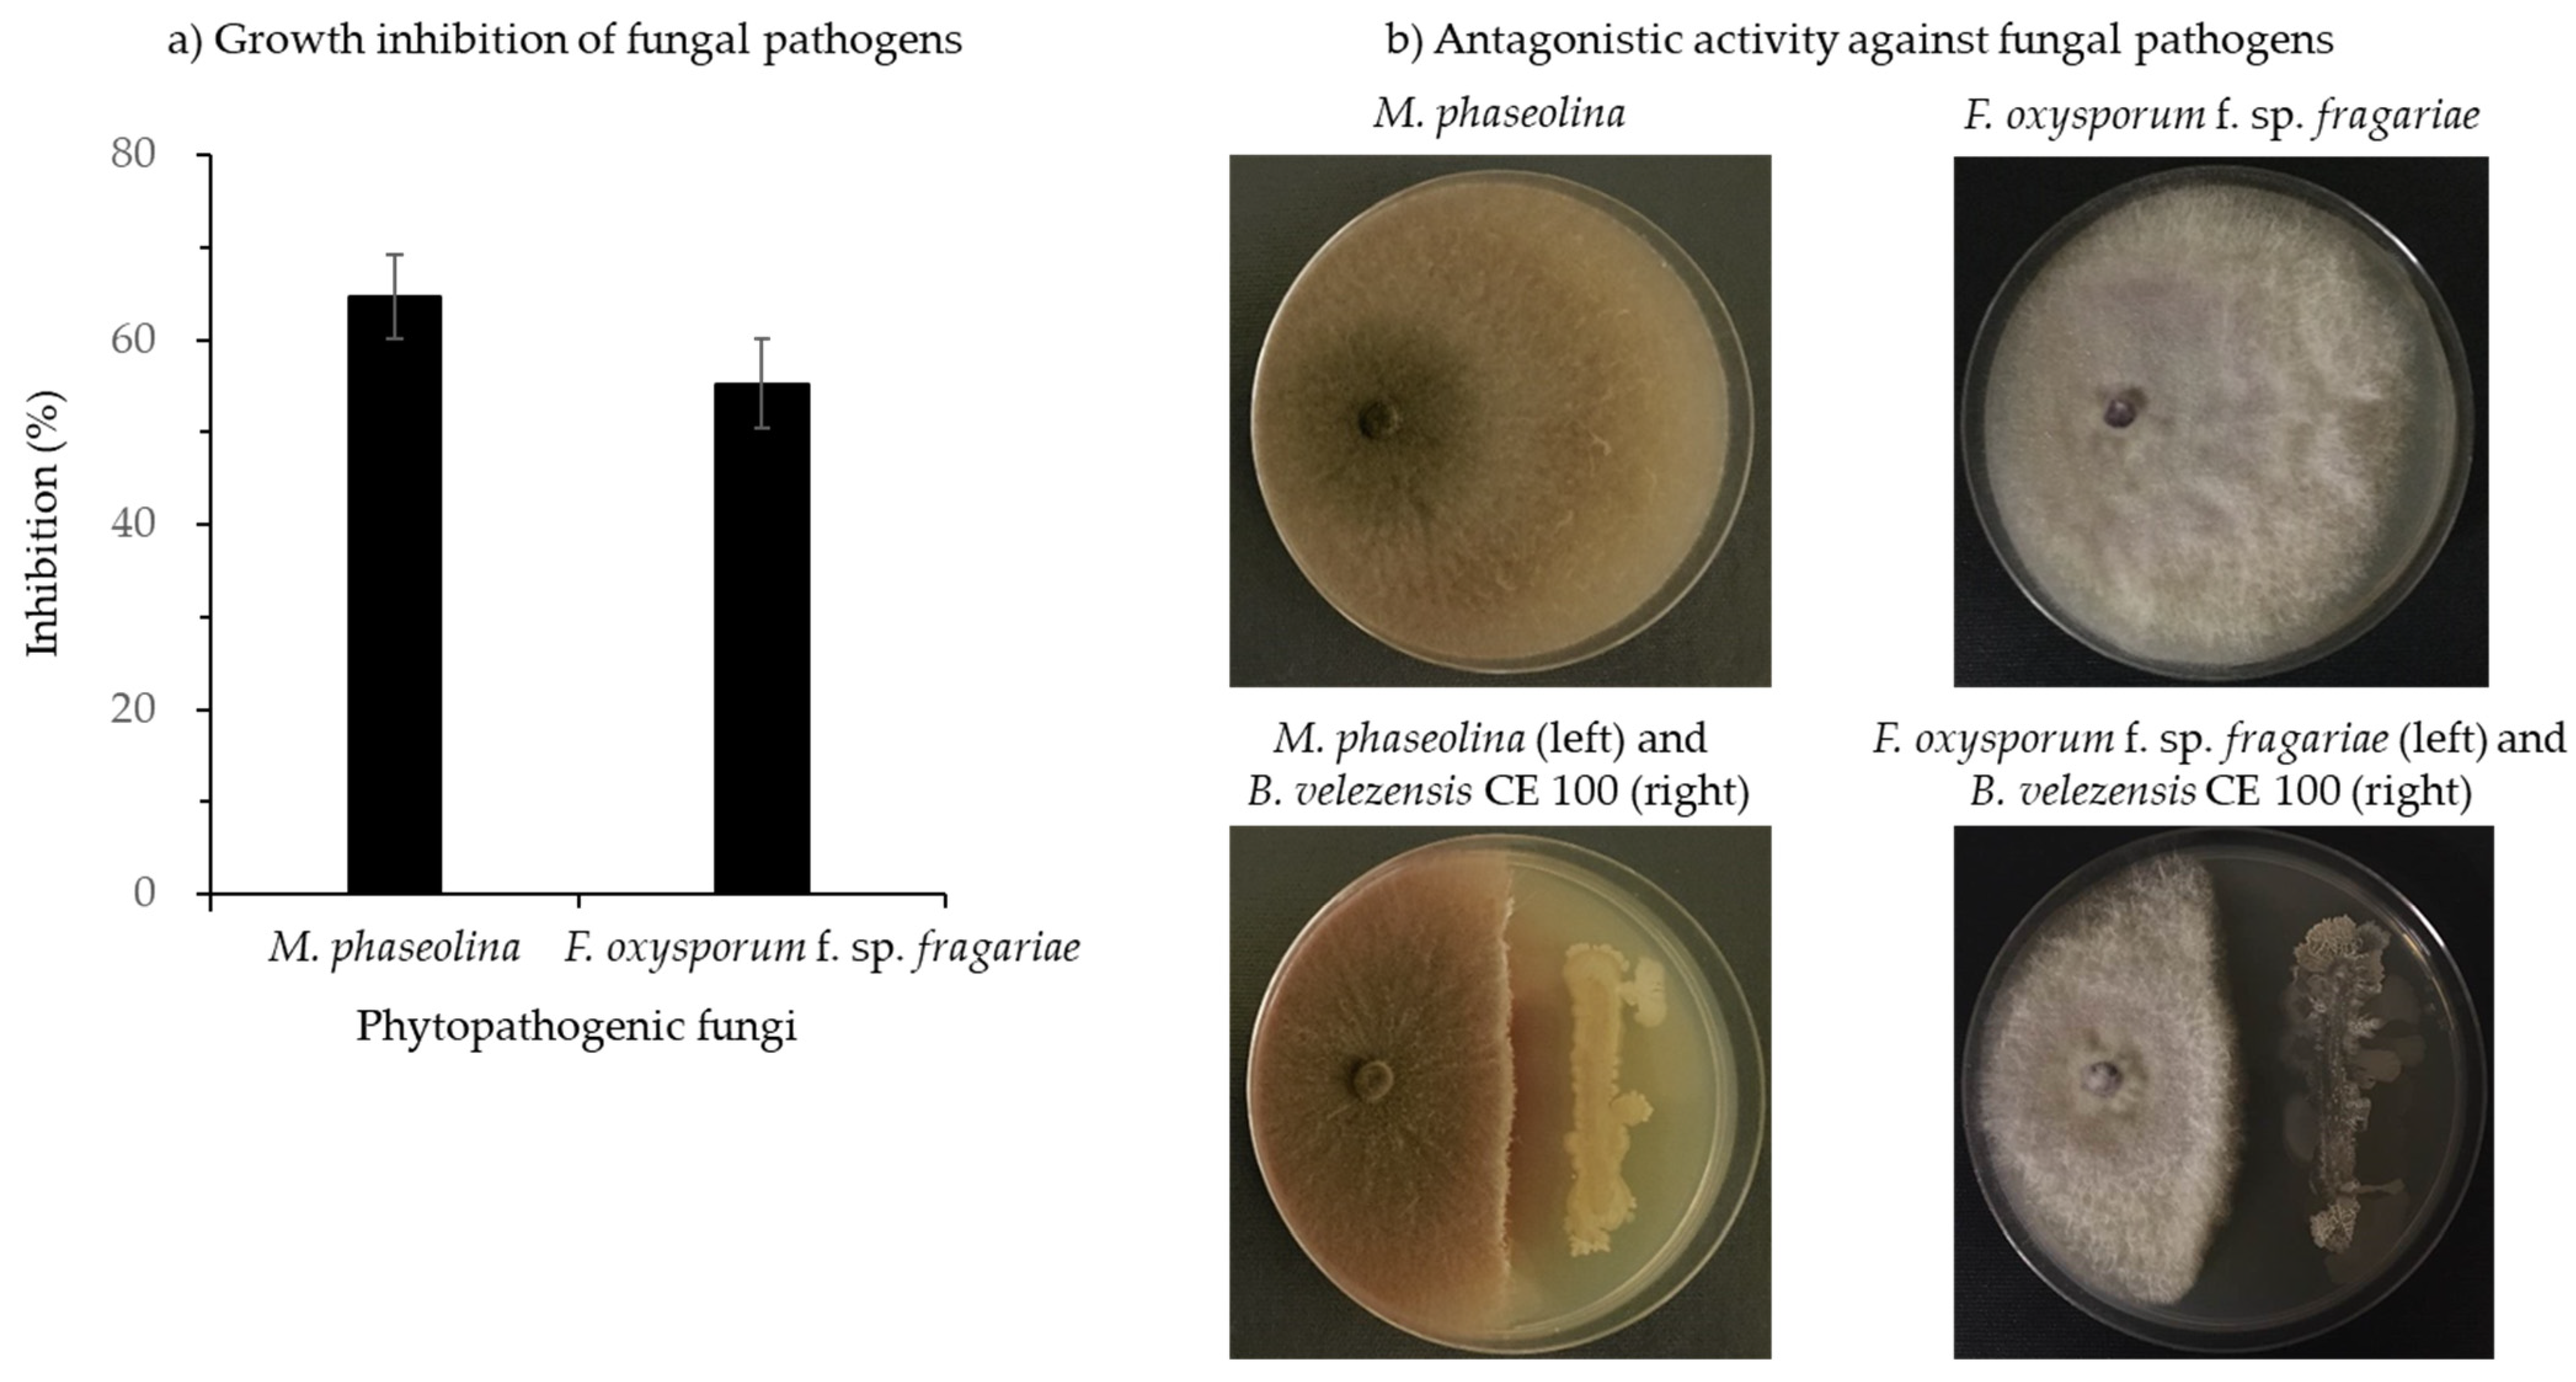
Microorganisms 10 00365 g003

Control of Fungal Diseases and Fruit Yield Improvement of Strawberry Using Bacillus velezensis CE 100
Abstract
1. Introduction
2. Materials and Methods
2.1. Growth of Bacillus velezensis CE 100
2.2. Production of Chitinase and β-1,3-Glucanase by Bacillus velezensis CE 100
2.3. Antagonistic Activity of Bacillus velezensis CE 100 against Fungal Pathogens
2.4. Quantitative Analysis of Indole-3-Acetic Acid (IAA) Produced by Bacillus velezensis CE 100
2.5. Growth of Strawberry Seedlings under Greenhouse Experimental Conditions
2.6. Measurement of Strawberry Growth and Fruit Yield
2.7. Statistical Analysis
3. Results
3.1. Inhibitory Effect of Bacillus velezensis CE 100 against Strawberry Fungal Pathogens
3.1.1. Cell Growth of Bacillus velezensis CE 100
3.1.2. Chitinase and β-1,3-Glucanase Activity of Bacillus velezensis CE 100
3.1.3. Antagonistic Activity of Bacillus velezensis CE 100 against Fungal Pathogens
3.2. Production of Indole-3-Acetic Acid (IAA) by Bacillus velezensis CE 100
3.3. Effect of Bacillus velezensis CE 100 on Fruit Yield
4. Discussion
4.1. Antagonism of Macrophomina phaseolina and Fusarium oxysporum by Cell Wall-Degrading Enzymes Produced by Bacillus velezensis CE 100
4.2. Effects of Bacillus velezensis CE 100 on Strawberry Growth and Fruit Production
5. Conclusions
Author Contributions
Funding
Institutional Review Board Statement
Informed Consent Statement
Data Availability Statement
Acknowledgments
Conflicts of Interest
References
- Simpson, D. The Economic Importance of Strawberry Crops. In The Genomes of Rosaceous Berries and Their Wild Relatives. Compendium of Plant Genomes; Hytönen, T., Graham, J., Harrison, R., Eds.; Springer Nature Switzerland AG: Cham, Switzerland, 2018; Volume 43, pp. 1–7. [Google Scholar] [CrossRef]
- Afrin, S.; Gasparrini, M.; Forbes-Hernandez, T.Y.; Reboredo-Rodriguez, P.; Mezzetti, B.; Varela-López, A.; Giampieri, F.; Battino, M. Promising health benefits of the strawberry: A focus on clinical studies. J. Agric. Food Chem. 2016, 64, 4435–4449. [Google Scholar] [CrossRef] [PubMed]
- FAOSTAT. Food and Agriculture Data. Available online: http://www.fao.org/faostat/en/#data/QC/visualize (accessed on 7 October 2021).
- Lee, W.S. Production of ever-bearing strawberry and production technology in Korea. Acta Hortic. 2014, 1049, 561–564. [Google Scholar] [CrossRef]
- Ruan, J.; Lee, Y.H.; Yeoung, Y.R. Flowering and fruiting of day-neutral and ever-bearing strawberry cultivars in high-elevation for summer and autumn fruit production in Korea. Hortic. Environ. Biotechnol. 2013, 54, 109–120. [Google Scholar] [CrossRef]
- Pastrana, A.M.; Basallote-Ureba, M.J.; Aguado, A.; Akdi, K.; Capote, N. Biological control of strawberry soil-borne pathogens Macrophomina phaseolina and Fusarium solani, using Trichoderma asperellum and Bacillus spp. Phytopathol. Mediterr. 2016, 55, 109–120. [Google Scholar] [CrossRef]
- Hutton, D.G.; Gomez, A.O.; Mattner, S.W. Macrophomina phaseolina and its association with strawberry crown rot in Australia. Int. J. Fruit Sci. 2013, 13, 149–155. [Google Scholar] [CrossRef]
- Koike, S.T.; Gordon, T.R. Management of fusarium wilt of strawberry. Crop Prot. 2015, 73, 67–72. [Google Scholar] [CrossRef]
- Nam, M.-H.; Park, M.-S.; Kim, H.-G.; Yoo, S.-J. Biological control of strawberry fusarium wilt caused by Fusarium oxysporum f. sp. fragariae using Bacillus velezensis BS87 and RK1 formulation. J. Microbiol. Biotechnol. 2009, 19, 520–524. [Google Scholar] [CrossRef]
- Zveibil, A.; Mor, N.; Gnayem, N.; Freeman, S. Survival, host-pathogen interaction, and management of Macrophomina phaseolina on strawberry in Israel. Plant Dis. 2012, 96, 265–272. [Google Scholar] [CrossRef]
- Koike, S.T.; Gordon, T.R.; Daugovish, O.; Ajwa, H.; Bolda, M.; Subbarao, K. Recent developments on strawberry plant collapse problems in California caused by Fusarium and Macrophomina. Int. J. Fruit Sci. 2013, 13, 76–83. [Google Scholar] [CrossRef]
- Kaur, S.; Dhillon, G.S.; Brar, S.K.; Vallad, G.E.; Chand, R.; Chauhan, V.B. Emerging phytopathogen Macrophomina phaseolina: Biology, economic importance, and current diagnostic trends. Crit. Rev. Microbiol. 2012, 38, 136–151. [Google Scholar] [CrossRef]
- Koike, S.T. Crown rot of strawberry caused by Macrophomina phaseolina in California. Plant Dis. 2008, 92, 1253. [Google Scholar] [CrossRef]
- Baggio, J.S.; Cordova, L.G.; Peres, N.A. Sources of inoculum and survival of Macrophomina phaseolina in Florida strawberry fields. Plant Dis. 2019, 103, 2417–2424. [Google Scholar] [CrossRef] [PubMed]
- Fang, X.; Kuo, J.; You, M.P.; Finnegan, P.M.; Barbetti, M.J. Comparative root colonization of strawberry cultivars Camarosa and Festival by Fusarium oxysporum f. sp. fragariae. Plant Soil 2012, 358, 75–89. [Google Scholar] [CrossRef]
- Rosskopf, E.N.; Chellemi, D.O.; Kokalis-Burelle, N.; Church, G.T. Alternatives to methyl bromide: A Florida perspective. Plant Health Prog. 2005, 6, 19. [Google Scholar] [CrossRef]
- Gemmill, A.; Gunier, R.B.; Bradman, A.; Eskenazi, B.; Harley, K.G. Residential proximity to methyl bromide use and birth outcomes in an agricultural population in California. Environ. Health Perspect. 2013, 121, 737–743. [Google Scholar] [CrossRef]
- Ajwa, H.A.; Klose, S.; Nelson, S.D.; Minuto, A.; Gullino, M.L.; Lamberti, F.; Lopez-Aranda, J.M. Alternatives to methyl bromide in strawberry production in the United States of America and the Mediterranean region. Phytopathol. Mediterr. 2003, 42, 220–244. [Google Scholar]
- Ruzo, L.O. Physical, chemical and environmental properties of selected chemical alternatives for the pre-plant use of methyl bromide as a soil fumigant. Pest Manag. Sci. 2006, 62, 99–113. [Google Scholar] [CrossRef]
- Ajwa, H.; Ntow, W.J.; Qin, R.; Gao, S. Properties of soil fumigants and their fate in the environment. In Hayes’ Handbook of Pesticide Toxicology, 3rd ed.; Krieger, R., Ed.; Elsevier: San Diego, CA, USA, 2010; Chapter 9; pp. 315–330. [Google Scholar] [CrossRef]
- Deising, H.B.; Reimann, S.; Pascholati, S.F. Mechanisms, and significance of fungicide resistance. Braz. J. Microbiol. 2008, 39, 286–295. [Google Scholar] [CrossRef]
- Abbey, J.A.; Percival, D.; Abbey, L.; Asiedu, S.K.; Prithiviraj, B.; Schilder, A. Bio fungicides as an alternative to synthetic fungicide control of grey mold (Botrytis cinerea): Prospects and challenges. Biocontrol Sci. Technol. 2019, 29, 207–228. [Google Scholar] [CrossRef]
- Annunziata, A.; Vecchio, R. Organic farming and sustainability in food choices: An analysis of consumer preference in Southern Italy. Agric. Agric. Sci. Procedia 2016, 8, 193–200. [Google Scholar] [CrossRef]
- Yiridoe, E.K.; Bonti-Ankomah, S.; Martin, R.C. Comparison of consumer perceptions and preference toward organic versus conventionally produced foods: A review and update of the literature. Renew. Agric. Food Syst. 2005, 20, 193–205. [Google Scholar] [CrossRef]
- Kwon, J.-H.; Won, S.-J.; Moon, J.-H.; Lee, U.; Park, Y.-S.; Maung, C.E.H.; Ajuna, H.B.; Ahn, Y.S. Bacillus licheniformis PR2 controls fungal diseases and increases the production of jujube fruit under field conditions. Horticulturae 2021, 7, 49. [Google Scholar] [CrossRef]
- Choub, V.; Maung, C.E.H.; Won, S.-J.; Moon, J.-H.; Kim, K.Y.; Han, Y.S.; Cho, J.-Y.; Ahn, Y.S. Antifungal activity of cyclic tetrapeptide from Bacillus velezensis CE 100 against plant pathogen Colletotrichum gloeosporioides. Pathogens 2021, 10, 209. [Google Scholar] [CrossRef] [PubMed]
- Moon, J.-H.; Won, S.-J.; Maung, C.E.H.; Choi, J.-H.; Choi, S.-I.; Ajuna, H.B.; Ahn, Y.S. Bacillus velezensis CE 100 inhibits root rot diseases (Phytophthora spp.) and promotes the growth of Japanese cypress (Chamaecyparis obtusa Endlicher) seedlings. Microorganisms 2021, 9, 821. [Google Scholar] [CrossRef] [PubMed]
- Won, S.-J.; Kwon, J.-H.; Kim, D.-H.; Ahn, Y.S. The effect of Bacillus licheniformis MH48 on control of foliar fungal diseases and growth promotion of Camellia oleifera seedlings in the coastal reclaimed land of Korea. Pathogens 2019, 8, 6. [Google Scholar] [CrossRef] [PubMed]
- Choub, V.; Ajuna, H.B.; Won, S.-J.; Moon, J.-H.; Choi, S.-I.; Maung, C.E.H.; Kim, C.-W.; Ahn, Y.S. Antifungal activity of Bacillus velezensis CE 100 against anthracnose disease (Colletotrichum gloeosporioides) and growth promotion of walnut (Juglans regia L.) trees. Int. J. Mol. Sci. 2021, 22, 10438. [Google Scholar] [CrossRef]
- Won, S.-J.; Choub, V.; Kwon, J.-H.; Kim, D.-H.; Ahn, Y.S. The control of fusarium root rot and development of coastal pine (Pinus thunbergii Parl.) seedlings in a container nursery by use of Bacillus licheniformis MH48. Forests 2019, 10, 6. [Google Scholar] [CrossRef]
- Grinter, R.; Milner, J.; Walker, D. Bacteriocins active against plant pathogenic bacteria. Biochem. Soc. Trans. 2012, 40, 1498–1502. [Google Scholar] [CrossRef]
- Free, S.J. Fungal cell wall organization and biosynthesis. Adv. Genet. 2013, 81, 33–82. [Google Scholar] [CrossRef]
- Geoghegan, I.; Steinberg, G.; Gurr, S. The role of the fungal cell wall in the infection of plants. Trends Microbiol. 2017, 25, 957–967. [Google Scholar] [CrossRef]
- Cortés, J.C.G.; Curto, M.-Á.; Carvalho, V.S.; Pérez, P.; Ribas, J.C. The fungal cell wall as a target for the development of new antifungal therapies. Biotechnol. Adv. 2019, 37, 107352. [Google Scholar] [CrossRef] [PubMed]
- Georgopapadakou, N.H. Update on antifungals targeted to the cell wall: Focus on β-1, 3-glucan synthase inhibitors. Expert Opin. Investig. Drugs 2001, 10, 269–280. [Google Scholar] [CrossRef]
- Schönbichler, A.; Díaz-Moreno, S.M.; Srivastava, V.; McKee, L.S. Exploring the potential for fungal antagonism and cell wall attack by Bacillus subtilis natto. Front. Microbiol. 2020, 11, 521. [Google Scholar] [CrossRef] [PubMed]
- Meng, Q.; Jiang, H.; Hao, J.J. Effects of Bacillus velezensis strain BAC03 in promoting plant growth. Biol. Control 2016, 98, 18–26. [Google Scholar] [CrossRef]
- Sturz, A.V.; Christie, B.R.; Nowak, J. Bacterial endophytes: Potential role in developing sustainable systems of crop production. Crit. Rev. Plant Sci. 2000, 19, 1–30. [Google Scholar] [CrossRef]
- Cho, H.-T.; Lee, R.D.W. Auxin, the organizer of the hormonal/environmental signals for root hair growth. Front. Plant Sci. 2013, 4, 448. [Google Scholar] [CrossRef]
- Park, H.-G.; Lee, Y.-S.; Kim, K.-Y.; Park, Y.-S.; Park, K.-H.; Han, T.-H.; Park, C.-M.; Ahn, Y.S. Inoculation with Bacillus licheniformis MH48 promotes nutrient uptake in seedlings of the ornamental plant Camellia japonica grown in Korean reclaimed coastal lands. Hortic. Sci Technol. 2017, 35, 11–20. [Google Scholar] [CrossRef]
- Chen, X.; Wang, Y.; Gao, Y.; Gao, T.; Zhang, D. Inhibitory abilities of Bacillus isolates and their culture filtrates against the gray mold caused by Botrytis cinerea on postharvest fruit. Plant Pathol. J. 2019, 35, 425. [Google Scholar] [CrossRef]
- Joly, P.; Calteau, A.; Wauquier, A.; Dumas, R.; Beuvin, M.; Vallenet, D.; Crovadore, J.; Cochard, B.; Lefort, F.; Berthon, J.-Y. From strain characterization to field authorization: Highlights on Bacillus velezensis strain B25 beneficial properties for plants and its activities on phytopathogenic fungi. Microorganisms 2021, 9, 1924. [Google Scholar] [CrossRef]
- Choi, T.G.; Maung, C.E.H.; Lee, D.R.; Ajuna, H.B.; Lee, Y.S.; Kim, K.Y. Role of bacterial antagonists of fungal pathogens, Bacillus thuringiensis KYC and Bacillus velezensis CE 100 in control of root-knot nematode, Meloidogyne incognita and subsequent growth promotion of tomato. Biocontrol Sci. Technol. 2020, 30, 685–700. [Google Scholar] [CrossRef]
- Moon, J.-H.; Won, S.-J.; Maung, C.E.H.; Choi, J.-H.; Choi, S.-I.; Ajuna, H.B.; Ahn, Y.S.; Jo, Y.H. The Role of Lysobacter antibioticus HS124 on the control of fall webworm (Hyphantria cunea Drury) and growth promotion of Canadian poplar (Populus canadensis Moench) at Saemangeum reclaimed land in Korea. Microorganisms 2021, 9, 1580. [Google Scholar] [CrossRef]
- Henry, P.M.; Kirkpatrick, S.C.; Islas, C.M.; Pastrana, A.M.; Yoshisato, J.A.; Koike, S.T.; Daugovish, O.; Gordon, T.R. The population of Fusarium oxysporum f. sp. fragariae, cause of fusarium wilt of strawberry, in California. Plant Dis. 2017, 101, 550–556. [Google Scholar] [CrossRef][Green Version]
- Kim, Y.C.; Jung, H.; Kim, K.Y.; Park, S.K. An effective biocontrol bioformulation against Phytophthora blight of pepper using growth mixtures of combined chitinolytic bacteria under different field conditions. Eur. J. Plant Pathol. 2008, 120, 373–382. [Google Scholar] [CrossRef]
- Nakkeeran, S.; Saranya, N.; Senthilraja, C.; Renukadevi, P.; Krishnamoorthy, A.; El Enshasy, H.A.; Eldawi, H.; Malathi, V.; Salmen, S.H.; Ansari, M. Mining the genome of Bacillus velezensis VB7 (CP047587) for MAMP genes and non-ribosomal peptide synthetase gene clusters conferring antiviral and antifungal activity. Microorganisms 2021, 9, 2511. [Google Scholar] [CrossRef]
- Wu, L.; Wu, H.; Chen, L.; Yu, X.; Borriss, R.; Gao, X. Difficidin and bacilysin from Bacillus amyloliquefaciens FZB42 have antibacterial activity against Xanthomonas oryzae rice pathogens. Sci. Rep. 2015, 5, 12975. [Google Scholar] [CrossRef]
- Wang, F.; Xiao, J.; Zhang, Y.; Li, R.; Liu, L.; Deng, J. Biocontrol ability and action mechanism of Bacillus halotolerans against Botrytis cinerea causing grey mold in postharvest strawberry fruit. Postharvest Biol. Technol. 2021, 174, 111456. [Google Scholar] [CrossRef]
- Won, S.-J.; Moon, J.-H.; Ajuna, H.B.; Choi, S.-I.; Maung, C.E.H.; Lee, S.; Ahn, Y.S. Biological control of leaf blight disease caused by Pestalotiopsis maculans and growth promotion of Quercus acutissima Carruth container seedlings using Bacillus velezensis CE 100. Int. J. Mol. Sci. 2021, 22, 11296. [Google Scholar] [CrossRef]
- Kim, I.P.; Chung, K.-C. Production of an antifungal protein for control of Colletotrichum lagenarium by Bacillus amyloliquefaciens MET0908. FEMS Microbiol. Lett. 2004, 234, 177–183. [Google Scholar] [CrossRef]
- Dahiya, N.; Tewari, R.; Hoondal, G.S. Biotechnological aspects of chitinolytic enzymes: A review. Appl. Microbiol. Biotechnol. 2006, 71, 773–782. [Google Scholar] [CrossRef]
- Café-Filho, A.C.; Lopes, C.A.; Rossato, M. Management of Plant Disease Epidemics with Irrigation Practices. In Irrigation in Agroecosystems. Agroecology; Ondrasek, G., Ed.; Intech Open: London, UK, 2019; Volume 1, pp. 123–139. [Google Scholar] [CrossRef]
- Enders, T.A.; Strader, L.C. Auxin activity: Past, present, and future. Am. J. Bot. 2015, 102, 180–196. [Google Scholar] [CrossRef]

| Treatments | Plant Biomass (g/Plant) | Fruit Yield (g/Plant) | ||
|---|---|---|---|---|
| Shoot | Root | Total | ||
| Control | 1.1 ± 0.2 b | 1.2 ± 0.5 b | 2.4 ± 0.6 b | 1.6 ± 1.9 b |
| M. phaseolina | 1.4 ± 0.5 b | 1.5 ± 0.6 b | 2.9 ± 1.1 b | 2.2 ± 4.8 b |
| M. phaseolina with B. velezensis CE 100 | 8.7 ± 2.7 a | 2.1 ± 0.5 a | 10.8 ± 3.2 a | 32.3 ± 13.5 a |
| Control | 1.0 ± 0.3 b | 1.1 ± 0.4 b | 2.1 ± 0.6 b | 1.6 ± 2.0 b |
| F. oxysporum f. sp. fragariae | 1.1 ± 0.4 b | 1.4 ± 0.5 b | 2.5 ± 0.6 b | 5.2 ± 3.2 b |
| F. oxysporum f. sp. fragariae with B. velezensis CE 100 | 10.2 ± 3.9 a | 1.9 ± 0.4 a | 12.2 ± 4.0 a | 25.3 ± 7.7 a |
Publisher’s Note: MDPI stays neutral with regard to jurisdictional claims in published maps and institutional affiliations. |
© 2022 by the authors. Licensee MDPI, Basel, Switzerland. This article is an open access article distributed under the terms and conditions of the Creative Commons Attribution (CC BY) license (https://creativecommons.org/licenses/by/4.0/).
Share and Cite
Hong, S.; Kim, T.Y.; Won, S.-J.; Moon, J.-H.; Ajuna, H.B.; Kim, K.Y.; Ahn, Y.S. Control of Fungal Diseases and Fruit Yield Improvement of Strawberry Using Bacillus velezensis CE 100. Microorganisms 2022, 10, 365. https://doi.org/10.3390/microorganisms10020365
Hong S, Kim TY, Won S-J, Moon J-H, Ajuna HB, Kim KY, Ahn YS. Control of Fungal Diseases and Fruit Yield Improvement of Strawberry Using Bacillus velezensis CE 100. Microorganisms. 2022; 10(2):365. https://doi.org/10.3390/microorganisms10020365
Chicago/Turabian StyleHong, Sarah, Tae Yoon Kim, Sang-Jae Won, Jae-Hyun Moon, Henry B. Ajuna, Kil Yong Kim, and Young Sang Ahn. 2022. "Control of Fungal Diseases and Fruit Yield Improvement of Strawberry Using Bacillus velezensis CE 100" Microorganisms 10, no. 2: 365. https://doi.org/10.3390/microorganisms10020365
APA StyleHong, S., Kim, T. Y., Won, S.-J., Moon, J.-H., Ajuna, H. B., Kim, K. Y., & Ahn, Y. S. (2022). Control of Fungal Diseases and Fruit Yield Improvement of Strawberry Using Bacillus velezensis CE 100. Microorganisms, 10(2), 365. https://doi.org/10.3390/microorganisms10020365

